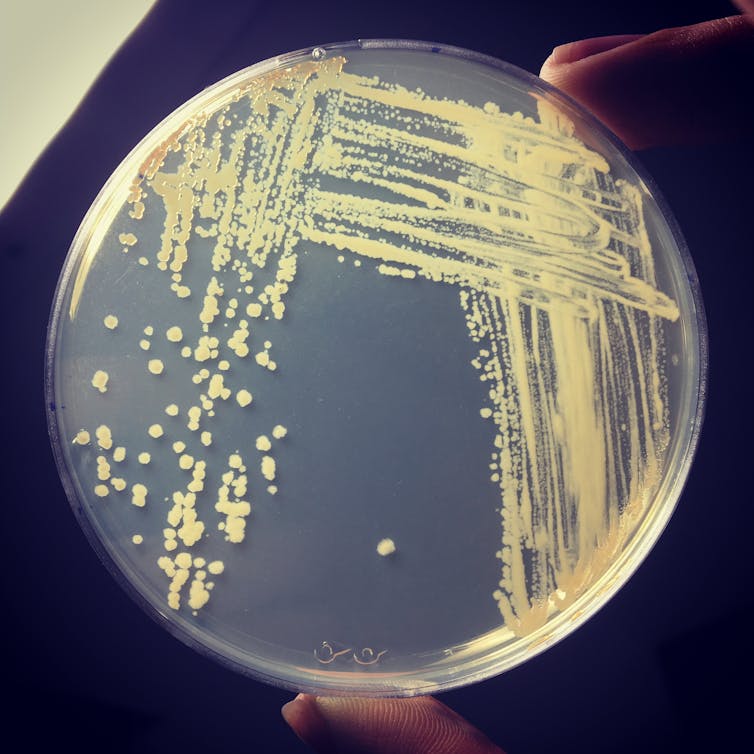
Energia dall'aria, i batteri come batterie naturali 4 Energia dall'aria, i batteri come batterie naturali 3

Può sembrare sorprendente, ma in casi di mancanza di cibo o in condizioni estremamente rigide, alcuni batteri sono in grado di estrarre energia dall’aria, trasformando l’idrogeno presente.
Oltre 70 milioni di questo gas sono infatti consumati dai batteri ogni anno, in un processo che cambia letteralmente l’aria che respiriamo.
I batteri che producono energia dall’aria
Partendo da questa meraviglia naturale, un gruppo di ricercatori della Monash University in Australia ha isolato un enzima che permette ad alcuni batteri aerobici, del genere Mycobacterium smegmatis, di “mangiare” idrogeno ed estrarne energia, tanto da poter produrre corrente elettrica anche solo alla minima esposizione al gas.
L’idrogenasi, l’enzima che rompe i legami tra i due protoni e i due elettroni di cui è composto l’idrogeno, fa sì che le due cariche positive si separino, mentre quelle negative siano rilasciate liberamente, producendo di fatto corrente elettrica.
Leggi anche: Carbon dot, il nuovo e performante look delle celle solari
Una vera forza della natura
Ancora più straordinaria la capacità dell’enzima, soprannominato dai ricercatori Huc, di sopravvivere in condizioni estreme, sia congelato che riscaldato oltre 80 gradi, cosa che lo rende perfettamente sfruttabile in qualsiasi condizione climatica.
Non solo, l’enzima continua a produrre energia dall’aria anche una volta isolato dal batterio che lo trasporta, in modo del tutto autonomo, persino in presenza di concentrazioni bassissime di idrogeno.
Il ritrovamento è affascite sotto molti punti di vista, ancor più se si considera che questi batteri potrebbero alimentare piccoli apparecchi che genererebbero in modo molto semplice energia dall’aria.
Leggi anche: Energia solare del Sahara, una nuova sfida verso la decarbonizzazione del vecchio continente
I batteri come batterie del domani

La sfida dei ricercatori è quella di rendere la produzione dell’enzima Huc scalabile, da milligrammi a chili, per essere certi che aumentando le quantità si preservino le caratteristiche testate in laboratorio.
La coltivazione dei batteri che contengono Huc è semplice e a basso rischio, l’unico limite è l’investimento economico iniziale per produrli in grandi quantità.
L’idea è quella di trasformare l’enzima in una sorta di batteria naturale, che possa produrre energia dall’aria o dalla somministrazione di idrogeno.
Anche se la quantità di idrogeno presente nell’aria è abbastanza modesta, le potenzialità di questa tecnologia sono infinite: apparecchi di piccole dimensioni, come schermi, led, monitor, tablet, pc ed elettrodomestici, potrebbero funzionare senza bisogno di altro che non essere esposti all’aria.
Leggi anche: Centrale solare orbitale, l’energia elettrica arriva direttamente dallo spazio
L’idrogeno, una risorsa importante

La scoperta dell’enzima Huc e della produzione di energia dall’aria si inserisce all’interno del più ampio panorama di ricerche collegate all’idrogeno come fonte rinnovabile, su cui puntano anche il Piano Next Generation Eu e il Pnrr in Italia.
Essendo uno dei gas più diffusi in natura, l’idrogeno costituisce un potenziale energetico di enormi dimensioni, sebbene il suo sfruttamento sia ancora in parte contestato a causa dei costi che richiede il suo utilizzo e dei problemi tecnici di applicazione.
Insieme al solare e all’eolico, tuttavia, l’idrogeno rappresenta un alleato importante nella lotta contro i combustibili fossili e i cambiamenti climatici, motivo per cui la ricerca, sebbene ancora agli inizi, porta a grandi risultati come quello di produrre energia dall’aria grazie ai batteri.
Leggi anche: L’Europa investe sull’idrogeno: fino al 14% in più di energia sostenibile

